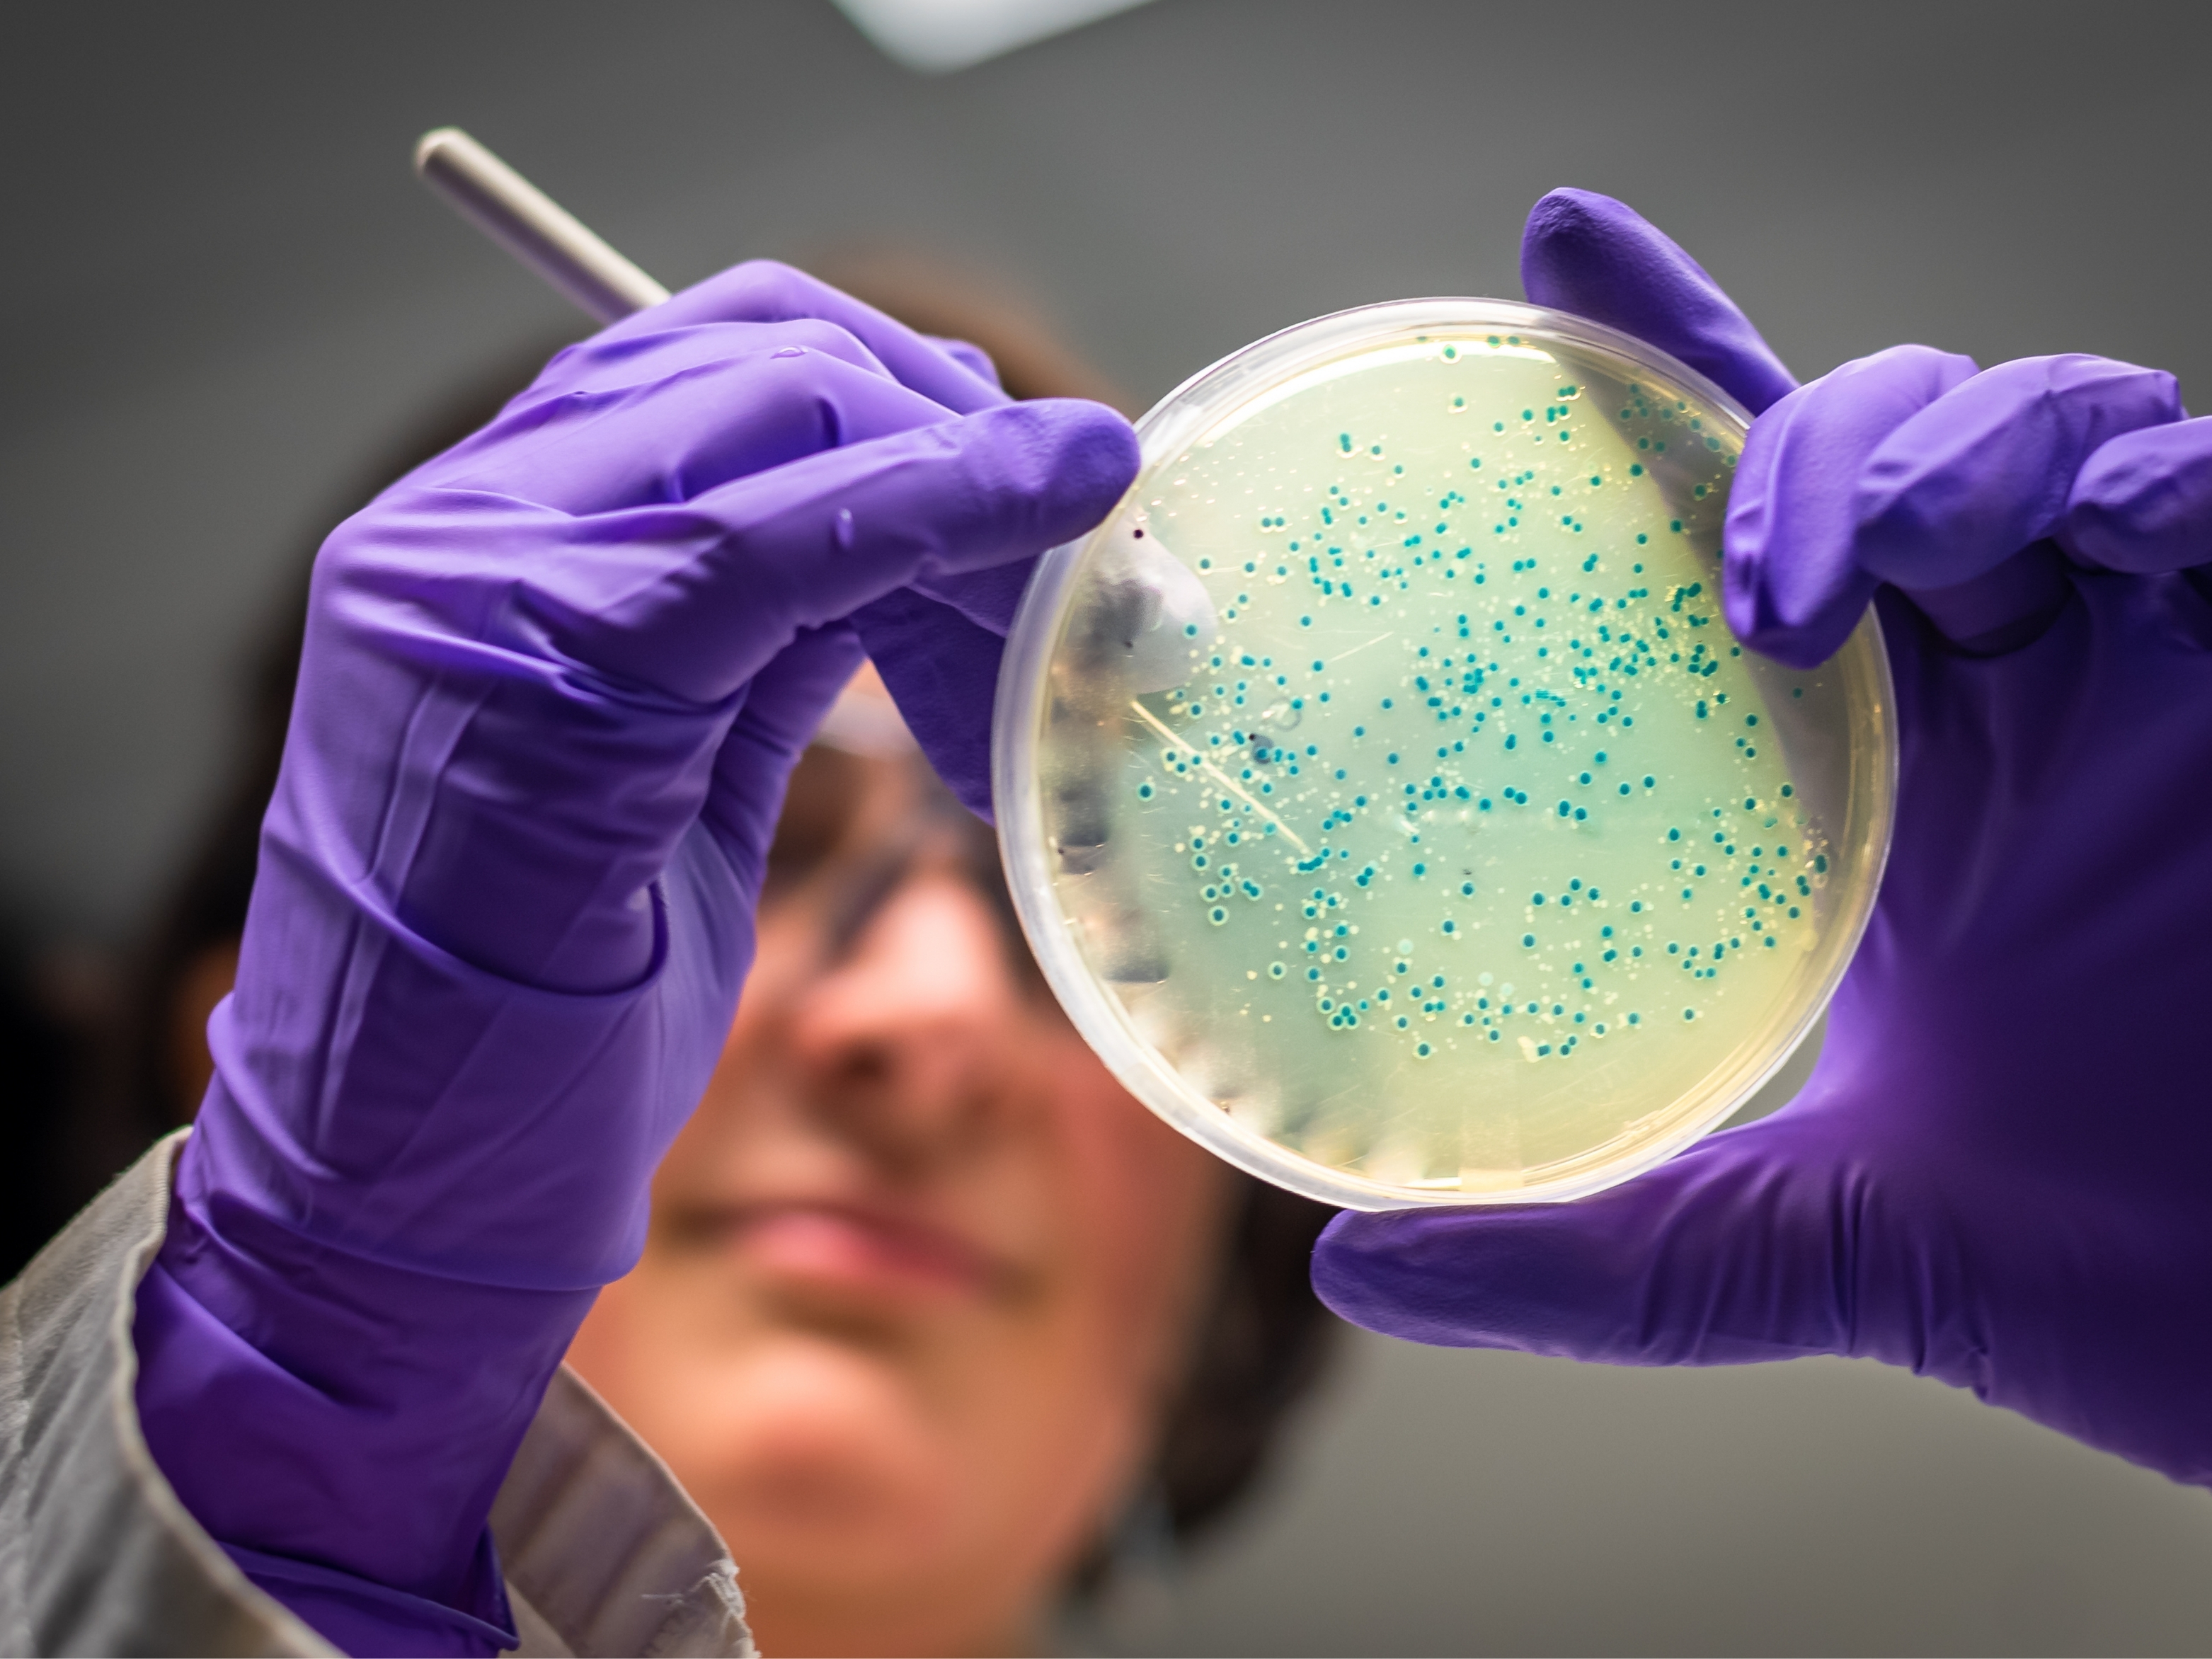
Kötü Anılar Artık Silinebilecek

Kötü Anılar Artık Silinebilecek
Bir hafıza silgisi mi? Hatırlamak istemediğiniz anıları seçerek “delete” tuşuna basmak mı? Yoksa, gelecekte bu türdeki anılara maruz kalmadan zihni kontrol edebilmek mi? Japon araştırmacıların hedefi zihin kontrolü değil, bağımlılık ya da travma sonrası yaşamı domine eden tetikleyicileri, psikoterapi protokollerinin yanında biyolojik bir ince ayarla daha yönetilebilir hale getirmek.
Japon araştırmacılar, optogenetik ışık uyarımı ile kemogenetik ilaç kontrollü sistemleri bir araya getirerek hafıza depolamayla ilişkili sinir devrelerini hedefliyor. Fare çalışmalarında bu devrelerin milisaniyelik zamanlamayla modüle edilmesi, belirli deneyimlerin geri çağrımını seçici biçimde zayıflatabiliyor; yani anılar tam anlamıyla silinmiyor, erişim eşiği yükseliyor ve duygusal şiddet kısılıyor. Buradaki hedef, zihin kontrolü değil; PTSD, bağımlılık ya da travma sonrası yaşamı domine eden tetikleyicileri, psikoterapi protokollerinin yanında biyolojik bir ince ayarla daha yönetilebilir hale getirmek. İnsan uygulamasına henüz geçilmedi…
Gen aktarımı, invaziv fiber optikler ve güvenlik-etik hatları nedeniyle süreç hâlâ deneysel kulvarda. Bu arada, nöron dışı oyuncuların (ör. astrositler) devre kimyasını ayarlayabildiğine dair bulgular ve öğrenme-sönme pencerelerini etkileyen yaşam tarzı unsurları (uyku, egzersiz, stres regülasyonu) klinik tasarımlara ipucu veriyor. Kısacası bugün masada bir hafıza silgisi yok; ama hatırlamanın valansını ve erişilebilirliğini ayarlayan, terapilere eşlik eden yeni nesil bir nöromodülasyon dili filizleniyor.

Özlem Yılmaz Küçük
0 Yorum
Yorum Gönder
Trend Haberler
Yazarlarımız
E-Bülten Aboneliği
E-Bülten Aboneliği Yaptığınız Zaman Son Gelişmelerden Anında Haberdar Olursunuz.!


Benzer Haberler
50 Yaş Üstü ve Kiloluysanız Risk İki Kat: Kolon Kanseri Sessizce İlerliyor
Mucize Zayıflama mı, Sessiz Tehlike mi? Uzmanlardan Zayıflama İğnesi Uyarısı
Kore Güzellik Trendinin Yeni Sırrı: Fiddy Metodu
Biohacking Kadınları Neden Yarı Yolda Bırakıyor?
Uzun Süreli Açlıkta Vücut Kendini Temizliyor: İşte Otofajinin Bilimsel Gerçeği
Bel Ağrısından Hormonal Dengeye: Meridyen Terapisi Neden Bu Kadar Etkili?
Basit Sanılan İshal Tehlikeli Olabilir: Kış Aylarında Çocuklarda Gastroenterit Alarmı
Zehirlenmelere Dikkat: En Büyük Tehlike Salmonella